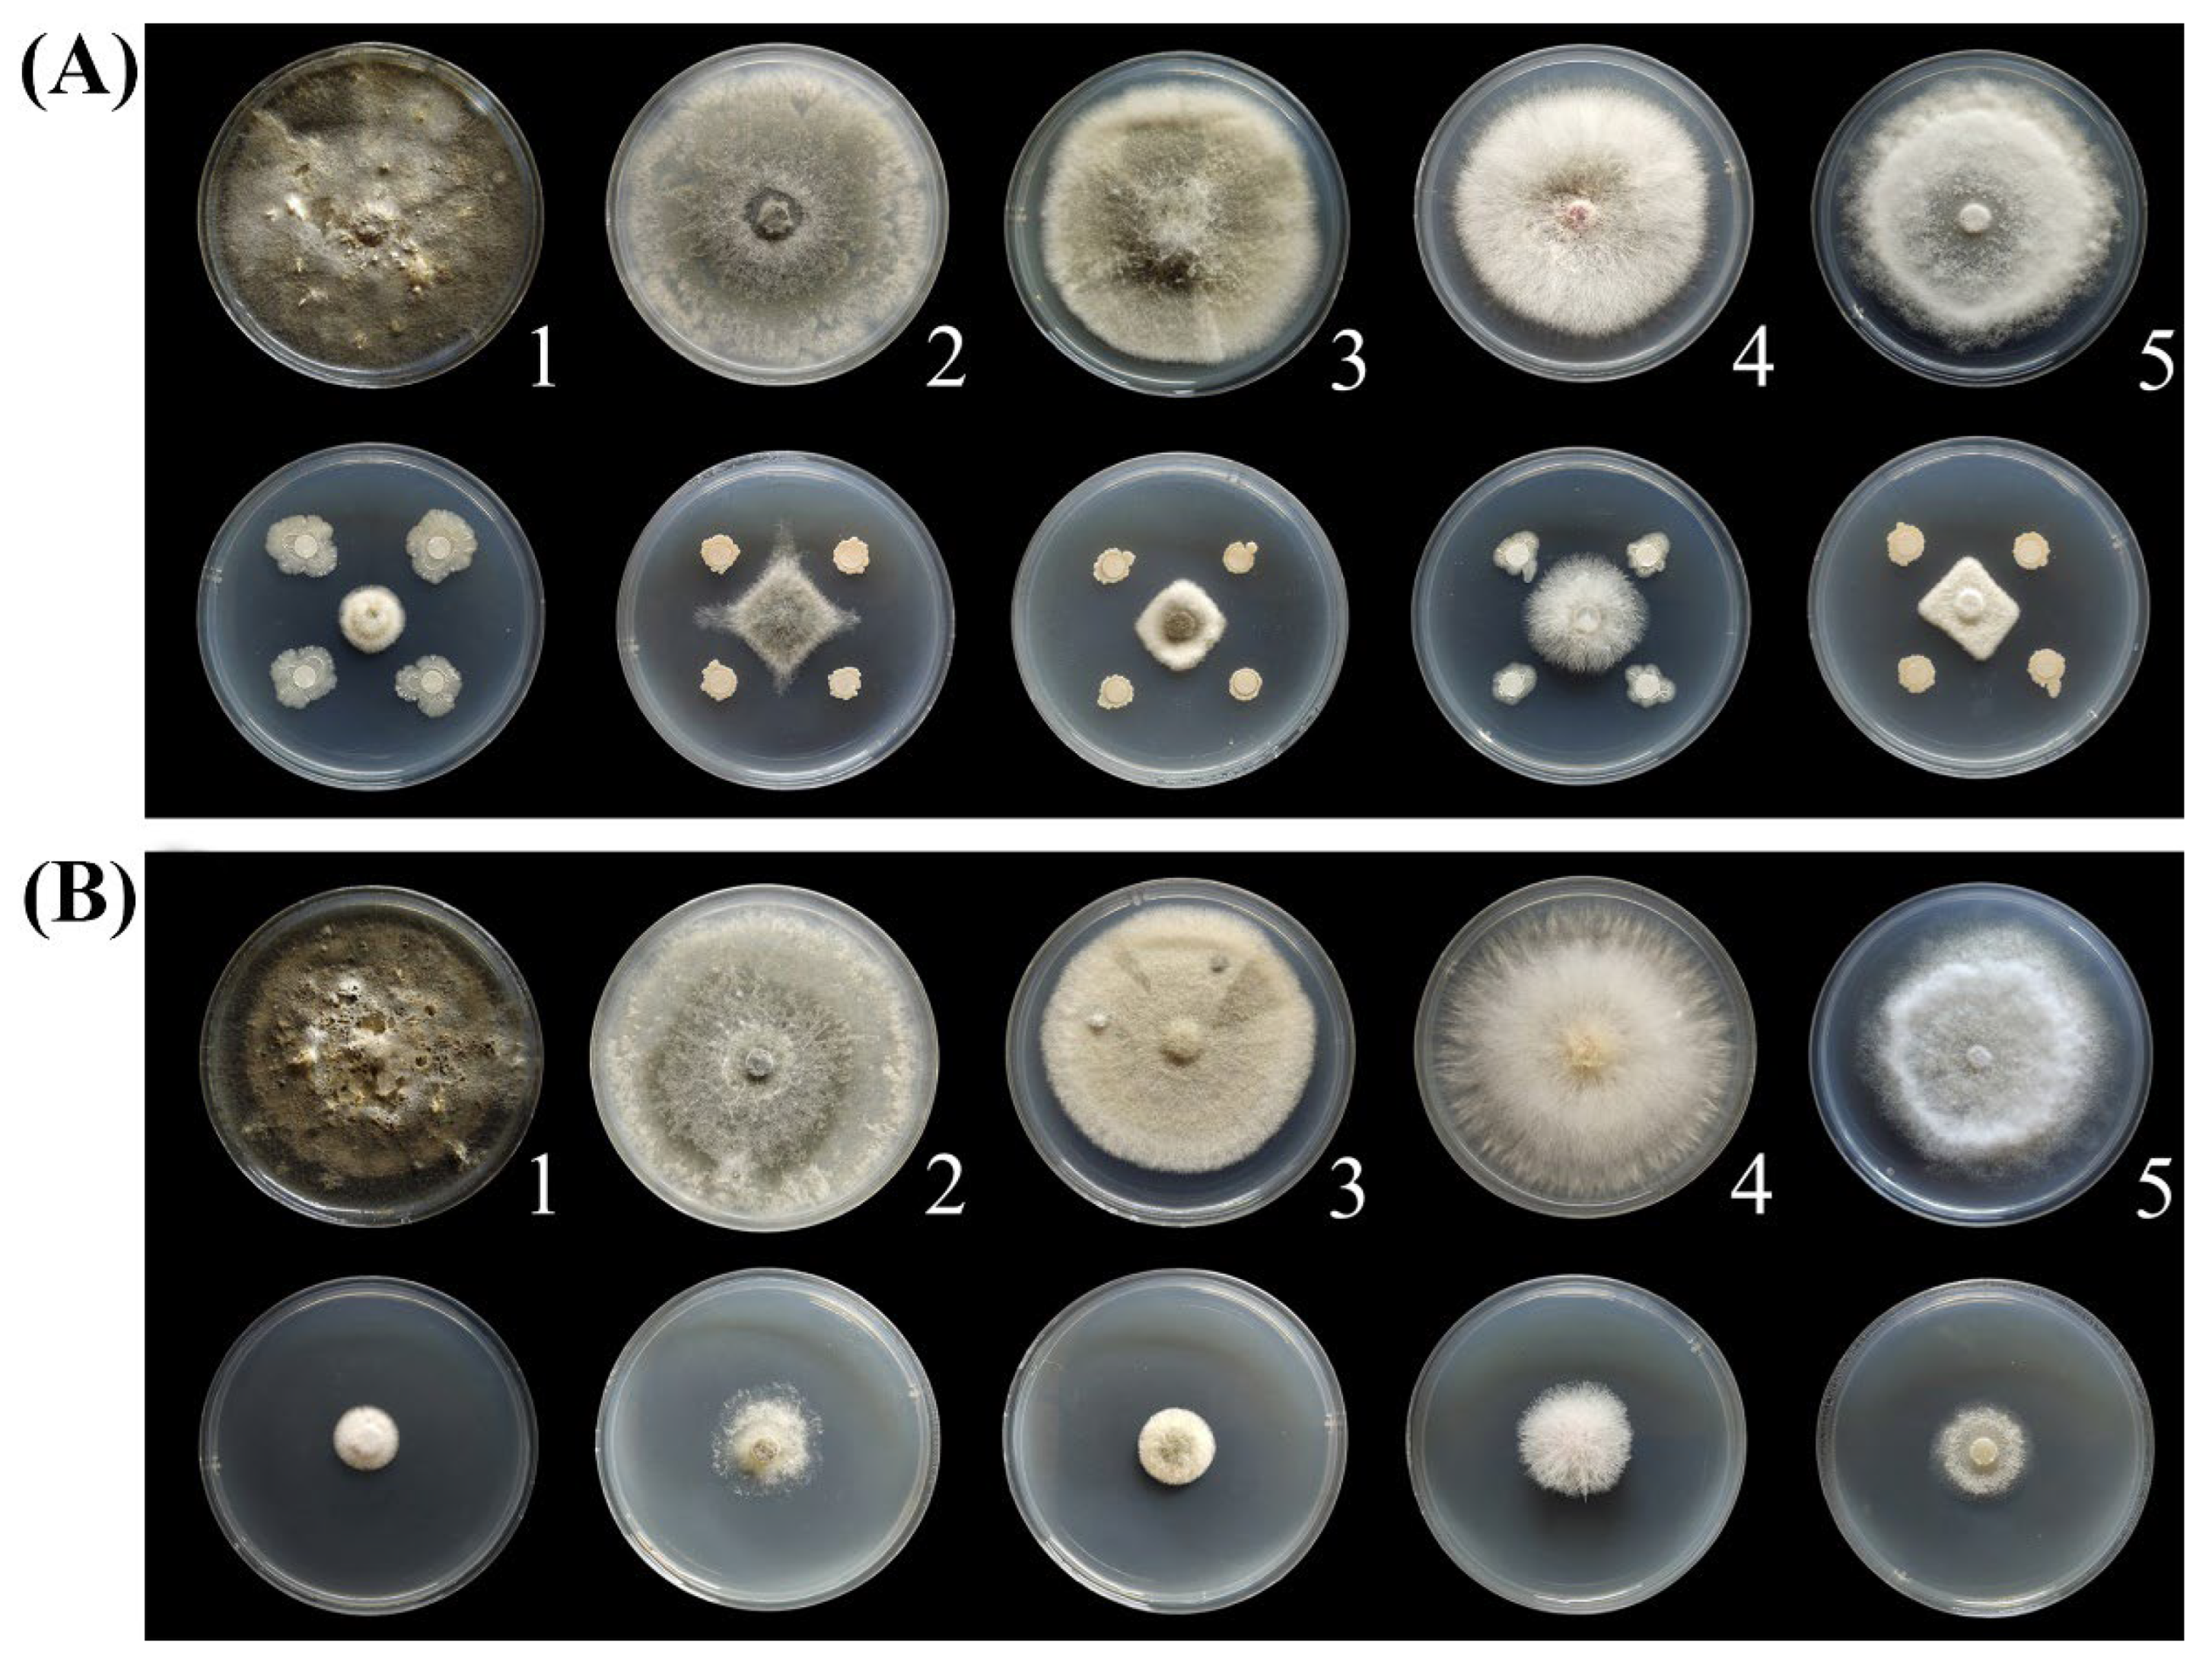

Antifungal Activities of Bacillus mojavensis BQ-33 towards the Kiwifruit Black Spot Disease Caused by the Fungal Pathogen Didymella glomerata
Abstract
1. Introduction
2. Materials and Methods
2.1. Fungal Pathogen
2.2. Rhizobacteria Isolation and Antifungal Activity Evaluation
2.3. Identification of the BQ-33 Strain
2.4. Preparation of QB-33 the Sterile Supernatant (SS)
2.5. Test of Antifungal Activity of BQ-33 and Its SS
2.6. Chitinase and β-1,3-Glucanase Activity Assays
2.7. Changes in Cell Permeability
2.8. Effects of SS on Cell Structures of Fungal Pathogens
2.8.1. Effects on Cell Walls
2.8.2. Effects on Cell Membranes
2.9. In Vivo Control Effect of SS
2.10. Statistical Analyses
3. Results
3.1. Screening of Biocontrol Bacteria
3.2. Identification of Strain BQ-33
3.3. Antifungal Spectrum of BQ-33 Regarding Kiwifruit Diseases
3.4. Enzymatic Activities of BQ-33 SS
3.5. Effect of SS on the Permeability of D. glomerata Cells
3.6. BQ-33 SS Influence on Fungal Cells
3.7. Biocontrol Efficacy of BQ-33 SS towards Kiwifruit Black Spot Disease
4. Discussion
Supplementary Materials
Author Contributions
Funding
Data Availability Statement
Acknowledgments
Conflicts of Interest
References
- Boeing, H.; Bechthold, A.; Bub, A.; Ellinger, S.; Haller, D.; Kroke, A.; Leschik-Bonnet, E.; Müller, M.J.; Oberritter, H.; Schulze, M.; et al. Critical review: Vegetables and fruit in the prevention of chronic diseases. Eur. J. Nutr. 2012, 51, 637–663. [Google Scholar] [CrossRef]
- Kumarihami, H.M.P.C.; Kim, J.G.; Kim, Y.H.; Lee, M.; Lee, Y.S.; Kwack, Y.B.; Kim, J. Preharvest application of chitosan improves the postharvest life of ‘Garmrok’ kiwifruit through the modulation of genes related to ethylene biosynthesis, cell wall modification and lignin metabolism. Foods 2021, 10, 373. [Google Scholar] [CrossRef]
- Richardson, D.P.; Ansell, J.; Drummond, L.N. The nutritional and health attributes of kiwifruit: A review. Eur. J. Nutr. 2018, 57, 2659–2676. [Google Scholar] [CrossRef]
- Zhao, L.; Cao, M.; Huang, Q.; Jing, M.; Bao, W.; Zhang, Y.; Hou, C.; Wu, Y.; Wang, Q. Occurrence and molecular characterization of Actinidia virus C (AcVC), a novel vitivirus infecting kiwifruit (Actinidia spp.) in China. Plant Pathol. 2020, 69, 775–782. [Google Scholar] [CrossRef]
- Yang, Y.; Chen, L.; Wang, C.; Peng, H.; Yin, W.; Li, R.; Liu, C.; Ren, X.; Ding, Y. Pathogenic fungi diversity of ‘CuiXiang’ kiwifruit black spot disease during storage. Horticultura 2022, 8, 13. [Google Scholar] [CrossRef]
- Pan, H.; Chen, M.; Deng, L.; Wang, Z.; Li, L.; Zhong, C. First report of Didymella glomerata causing black spot disease of kiwifruit in China. Plant Dis. 2018, 102, 2654. [Google Scholar] [CrossRef]
- Huang, S.; Wang, L.; Wang, T.; Jiao, Z.; Pang, F.; Tao, A.; Niu, X.; Lu, W. First report of Didymella leaf blight on Cornus officinalis caused by Didymella glomerata in China. Plant Dis. 2018, 102, 1031. [Google Scholar] [CrossRef]
- Moral, J.; Lichtemberg, P.S.F.; Papagelis, A.; Sherman, J.; Michailides, T.J. Didymella glomerata causing leaf blight on pistachio. Eur. J. Plant Pathol. 2018, 151, 1095–1099. [Google Scholar] [CrossRef]
- Song, L.; Jiang, N.; Tan, G.; Chen, Q.; Feng, S.; Zhang, Z. First report of round leaf spot on Sophora tonkinensis caused by Didymella glomerata in China. Plant Dis. 2020, 105, 498. [Google Scholar] [CrossRef]
- Cimmino, A.; Bahmani, Z.; Masi, M.; Abdollahzadeh, J.; Amini, J.; Tuzi, A.; Evidente, A. Phytotoxins produced by Didymella glomerata and Truncatella angustata, associated with grapevine trunk diseases (GTDs) in Iran. Nat. Prod. Res. 2021, 20, 4316–4323. [Google Scholar] [CrossRef]
- Ma, W.; Yang, J.; Gao, X.; Han, T.; Liu, J.; Ding, J.; Zhao, W.; Peng, Y.; Bhadauria, V. First report of Didymella glomerata causing Didymella leaf blight on maize in China. Plant Dis. 2022, 106, 2522. [Google Scholar] [CrossRef] [PubMed]
- Thomidis, T.; Exadaktylou, E.; Chen, S. Diaporthe neotheicola, a new threat for kiwifruit in Greece. Crop Prot. 2013, 47, 35–40. [Google Scholar] [CrossRef]
- Bardas, G.A.; Veloukas, T.; Koutita, O.; Karaoglanidis, G.S. Multiple resistance of Botrytis cinerea from kiwifruit to SDHIs, QoIs and fungicides of other chemical groups. Pest Manag. Sci. 2010, 66, 967–973. [Google Scholar] [CrossRef]
- Fira, D.; Dimkić, I.; Berić, T.; Lozo, J.; Stanković, S. Biological control of plant pathogens by Bacillus species. J. Biotechnol. 2018, 285, 44–55. [Google Scholar] [CrossRef] [PubMed]
- Köhl, J.; Kolnaar, R.; Ravensberg, W.J. Mode of action of microbial biological control agents against plant diseases: Relevance beyond efficacy. Front. Plant Sci. 2019, 10, 845. [Google Scholar] [CrossRef] [PubMed]
- van Lenteren, J.C.; Bolckmans, K.; Köhl, J.; Ravensberg, W.J.; Urbaneja, A. Biological control using invertebrates and microorganisms: Plenty of new opportunities. BioControl 2018, 63, 39–59. [Google Scholar] [CrossRef]
- Feliziani, E.; Lichter, A.; Smilanick, J.L.; Ippolito, A. Disinfecting agents for controlling fruit and vegetable diseases after harvest. Postharvest Biol. Technol. 2016, 122, 53–69. [Google Scholar] [CrossRef]
- Blake, C.; Christensen, M.N.; Kovács, Á.T. Molecular aspects of plant growth promotion and protection by Bacillus subtilis. Mol. Plant-Microbe Interact. 2021, 34, 15–25. [Google Scholar] [CrossRef] [PubMed]
- Papoutsis, K.; Mathioudakis, M.M.; Hasperué, J.H.; Ziogas, V. Non-chemical treatments for preventing the postharvest fungal rotting of citrus caused by Penicillium digitatum (green mold) and Penicillium italicum (blue mold). Trends Food Sci. Technol. 2019, 86, 479–491. [Google Scholar] [CrossRef]
- Mateus, J.R.; Dal’Rio, I.; Jurelevicius, D.; da Mota, F.F.; Marques, J.M.; Ramos, R.T.; da Silva, A.L.D.; Gagliardi, P.R.; Seldin, L. Bacillus velezensis T149-19 and Bacillus safensis T052-76 as potential biocontrol agents against foot rot disease in sweet potato. Agriculture 2021, 11, 1046. [Google Scholar] [CrossRef]
- Ramirez, V.; Martínez, J.; Bustillos-Cristales, M.; Catañeda-Antonio, D.; Munive, J.A.; Baez, A. Bacillus cereus MH778713 elicits tomato plant protection against Fusarium oxysporum. J. Appl. Microbiol. 2021, 132, 470–482. [Google Scholar] [CrossRef]
- Villa-Rodríguez, E.; Parra-Cota, F.; Castro-Longoria, E.; López-Cervantes, J.; Santos-Villalobos, S.D. Bacillus subtilis TE3: A promising biological control agent against Bipolaris sorokiniana, the causal agent of spot blotch in wheat (Triticum turgidum L. subsp. durum). Biol. Control 2019, 132, 135–143. [Google Scholar] [CrossRef]
- Gowtham, H.G.; Murali, M.; Singh, S.B.; Lakshmeesha, T.R.; Murthya, K.N.; Amruthesh, K.N.; Niranjana, S.R. Plant growth promoting rhizobacteria- Bacillus amyloliquefaciens improves plant growth and induces resistance in chilli against anthracnose disease. Biol. Control 2018, 126, 209–217. [Google Scholar] [CrossRef]
- Huang, C.; Xu, G.; Wang, L.; Zhang, P.; Zhao, P.; Zhong, Y. Antagonistic properties and screening of Bacillus Velezensis Nhw-B72 against wood fungal decay. Forests 2021, 12, 785. [Google Scholar] [CrossRef]
- Tan, T.; Zhu, J.; Shen, A.; Li, J.; Yu, Y.; Zhang, M.; Zhao, M.; Li, Z.; Chen, J.; Gao, C.; et al. Isolation and identification of a Bacillus subtilis HZ-72 exhibiting biocontrol activity against flax seedling blight. Eur. J. Plant Pathol. 2019, 153, 825–836. [Google Scholar] [CrossRef]
- Mamphogoro, T.P.; Kamutando, C.N.; Maboko, M.M.; Aiyegoro, O.A.; Babalola, O.O. Epiphytic bacteria from sweet pepper antagonistic in vitro to Ralstonia solanacearum BD 261, a causative agent of bacterial wilt. Microorganisms 2021, 9, 1947. [Google Scholar] [CrossRef]
- Yang, F.; Zhang, R.; Wu, X.; Xu, T.; Ahmad, S.; Zhang, X.; Zhao, J.; Liu, Y. An endophytic strain of the genus Bacillus isolated from the seeds of maize (Zea mays L.) has antagonistic activity against maize pathogenic strains. Microb. Pathogenesis 2020, 142, 104074. [Google Scholar] [CrossRef] [PubMed]
- Kumar, S.; Stecher, G.; Tamura, K. MEGA7: Molecular evolutionary genetics analysis version 7.0 for bigger datasets. Mol. Biol. Evol. 2016, 33, 1870–1874. [Google Scholar] [CrossRef]
- Chen, C.; Zheng, C.; Li, J.; Tao, C.; Feng, Y.; Han, Y. A novel endophytic strain of Lactobacillus plantarum CM-3 with antagonistic activity against Botrytis cinerea on strawberry fruit. Biol. Control 2020, 148, 104306. [Google Scholar] [CrossRef]
- Zheng, T.; Liu, L.; Nie, Q.; Hsiang, T.; Sun, Z.; Zhou, Y. Isolation, identification and biocontrol mechanisms of endophytic bacterium D61-A from Fraxinus hupehensis against Rhizoctonia solani. Biol. Control 2021, 158, 104621. [Google Scholar] [CrossRef]
- Tang, W.; Ding, Z.; Zhou, Z.; Wang, Y.; Guo, L. Phylogenetic and pathogenic analyses show that the causal agent of apple ring rot in China is Botryosphaeria dothidea. Plant Dis. 2012, 96, 486–496. [Google Scholar] [CrossRef] [PubMed]
- Long, H.; Yang, S.; Yin, X.; Zhao, Z.; Long, Y.; Fan, J.; Shu, R.; Gu, G. First report of leaf spot on Prunus salicina caused by Alternaria alternata in China. J. Plant Pathol. 2021, 103, 1021. [Google Scholar] [CrossRef]
- Jin, M.; Yang, C.; Liu, Z.; Wei, L.; Cui, L. First Report of Fusarium oxysporum Causing Root Rot on Chinese Chives in China. Plant Dis. 2019, 103, 2945. [Google Scholar] [CrossRef]
- Li, L.; Pan, H.; Chen, M.; Zhang, S.; Zhong, C. Isolation and identification of pathogenic fungi causing postharvest fruit rot of kiwifruit (Actinidia chinensis) in China. J. Phytopathol. 2017, 165, 782–790. [Google Scholar] [CrossRef]
- Hong, S.; Kim, T.Y.; Won, S.J.; Moon, J.H.; Ajuna, H.B.; Kim, K.Y.; Ahn, Y.S. Control of fungal diseases and fruit yield improvement of strawberry using Bacillus velezensis CE 100. Microorganisms 2022, 10, 365. [Google Scholar] [CrossRef]
- Moon, J.H.; Won, S.J.; Maung, C.E.; Choi, J.H.; Choi, S.I.; Ajuna, H.B.; Ahn, Y.S. Bacillus velezensis CE 100 inhibits root rot diseases (Phytophthora spp.) and promotes growth of japanese cypress (Chamaecyparis obtusa Endlicher) seedlings. Microorganisms 2021, 9, 821. [Google Scholar] [CrossRef] [PubMed]
- Mo, F.; Hu, X.; Ding, Y.; Li, R.; Long, Y.; Wu, X.; Li, M. Naturally produced magnolol can significantly damage the plasma membrane of Rhizoctonia solani. Pestic. Biochem. Phys. 2021, 178, 104942. [Google Scholar] [CrossRef] [PubMed]
- Chavan, P.S.; Tupe, S.G. Antifungal activity and mechanism of action of carvacrol and thymol against vineyard and wine spoilage yeasts. Food Control 2014, 46, 115–120. [Google Scholar] [CrossRef]
- Van de Wouw, A.P.; Pettolino, F.A.; Howlett, B.J.; Elliott, C.E. Mutations to LmIFRD affect cell wall integrity, development and pathogenicity of the ascomycete Leptosphaeria maculans. Fungal Genet. Biol. 2009, 46, 695–706. [Google Scholar] [CrossRef] [PubMed]
- Xin, Z.; Yang, Q.; Wan, C.; Che, J.; Li, L.; Chen, J.; Tao, N. Isolation of antofine from Cynanchum atratum BUNGE (Asclepiadaceae) and its antifungal activity against Penicillium digitatum. Postharvest Biol. Technol. 2019, 157, 110961. [Google Scholar] [CrossRef]
- Xu, Y.; Wang, L.; Liang, W.; Liu, M. Biocontrol potential of endophytic Bacillus velezensis strain QSE-21 against postharvest grey mould of fruit. Biol. Control 2021, 161, 104711. [Google Scholar] [CrossRef]
- Zhang, D.; Bi, W.; Kai, K.; Ye, Y.; Liu, J. Effect of chlorogenic acid on controlling kiwifruit postharvest decay caused by Diaporthe sp. LWT 2020, 132, 109805. [Google Scholar] [CrossRef]
- Ramarathnam, R.; Bo, S.; Chen, Y.; Fernando, D.; Gao, X.; Kievit, T.D. Molecular and biochemical detection of fengycin- and bacillomycin D-producing Bacillus spp., antagonistic to fungal pathogens of canola and wheat. Can. J. Microbiol. 2007, 53, 901–911. [Google Scholar] [CrossRef] [PubMed]
- Chowdhury, S.P.; Hartmann, A.; Gao, X.W.; Borriss, R. Biocontrol mechanism by root-associated Bacillus amyloliquefaciens FZB42 —A review. Front. Microbiol. 2015, 6, 780. [Google Scholar] [CrossRef]
- Galitskaya, P.; Karamova, K.; Biktasheva, L.; Galieva, G.; Gordeev, A.; Selivanovskaya, S. Lipopeptides produced by Bacillus mojavensis P1709 as an efficient tool to maintain postharvest cherry tomato quality and quantity. Agriculture 2022, 12, 609. [Google Scholar] [CrossRef]
- Bacon, C.W.; Hinton, D.M. In planta reduction of maize seedling stalk lesions by the bacterial endophyte Bacillus mojavensis. Can. J. Microbiol. 2011, 57, 485–492. [Google Scholar] [CrossRef]
- Kim, P.I.; Chung, K.C. Production of an antifungal protein for control of Colletotrichum lagenarium by Bacillus amyloliquefaciens MET0908. FEMS Microbiol. Lett. 2004, 234, 177–183. [Google Scholar] [CrossRef]
- Kim, Y.C.; Hur, J.Y.; Park, S.K. Biocontrol of Botrytis cinerea by chitin-based cultures of Paenibacillus elgii HOA73. Eur. J. Plant Pathol. 2019, 155, 253–263. [Google Scholar] [CrossRef]
- Asif, T.; Javed, U.; Zafar, S.B.; Ansari, A.; UI Qader, S.A.; Aman, A. Bioconversion of colloidal chitin using novel chitinase from Glutamicibacter uratoxydans exhibiting anti-fungal potential by hydrolyzing chitin within fungal cell wall. Waste Biomass Valori. 2020, 11, 4129–4143. [Google Scholar] [CrossRef]
- Ye, X.Y.; Ng, T.B. A new antifungal protein and a chitinase with prominent macrophage-stimulating activity from seeds of Phaseolus vulgaris cv. pinto. Biochem. Biophys. Res. Commun. 2002, 290, 813–819. [Google Scholar] [CrossRef]
- Hong, T.; Meng, M. Biochemical characterization and antifungal activity of an endo-1,3-β-glucanase of Paenibacillus sp. isolated from garden soil. Appl. Microbiol. Biot. 2003, 61, 472–478. [Google Scholar] [CrossRef] [PubMed]
- Bacon, C.W.; Hinton, D.M.; Mitchell, T.R.; Snook, M.E.; Olubajo, B. Characterization of endophytic strains of Bacillus mojavensis and their production of surfactin isomers. Biol. Control 2012, 62, 1–9. [Google Scholar] [CrossRef]
- Lai, T.; Wang, Y.; Fan, Y.; Zhou, Y.; Bao, Y.; Zhou, T. The response of growth and patulin production of postharvest pathogen Penicillium expansum to exogenous potassium phosphite treatment. Int. J. Food Microbiol. 2017, 244, 1–10. [Google Scholar] [CrossRef] [PubMed]
- Cox, S.D.; Mann, C.M.; Markham, J.L.; Gustafson, J.E.; Warmington, J.R.; Wyllie, S.G. Determining the antimicrobial actions of tea tree oil. Molecules 2001, 6, 87–91. [Google Scholar] [CrossRef]
- Shi, C.; Song, K.; Zhang, X.; Sun, Y.; Sui, Y.; Chen, Y.; Jia, Z.; Sun, H.; Sun, Z.; Xia, X. Antimicrobial activity and possible mechanism of action of citral against Cronobacter sakazakii. PLoS ONE 2016, 11, e0159006. [Google Scholar] [CrossRef]
- Diao, W.; Hu, Q.; Zhang, H.; Xu, J. Chemical composition, antibacterial activity and mechanism of action of essential oil from seeds of fennel (Foeniculum vulgare Mill.). Food Control 2014, 35, 109–116. [Google Scholar] [CrossRef]

| No. | Pathogen | Host Plant | Disease Type |
|---|---|---|---|
| 1 | Didymella glomerata | Kiwifriut | Black spot [6] |
| 2 | Botryosphaeria dothidea | Apple | Ring rot [31] |
| 3 | Alternaria alternata | Prunus salicina | Leaf spot [32] |
| 4 | Fusarium oxysporum | Gastrodia elata | Tuber rot [33] |
| 5 | Phomopsis cauloides | Kiwifriut | Soft rot [34] |
| Pathogen | Inhibition Ratio by BQ-33 Suspension (%) | Inhibition Ratio by SS (%) |
|---|---|---|
| Didymella glomerata | 81.26 ± 0.47 a | 83.43 ± 0.35 a |
| Botryosphaeria dothidea | 73.62 ± 1.43 c | 74.19 ± 0.59 c |
| Alternaria alternata | 77.45 ± 1.18 b | 78.86 ± 0.55 b |
| Fusarium oxysporum | 70.11 ± 0.92 d | 72.63 ± 0.56 c |
| Phomopsis cauloides | 75.73 ± 0.78 bc | 77.13 ± 0.67 b |
| Treatment | Lesion Diameter (mm) | Control Efficacy (%) |
|---|---|---|
| Control | 20.62 ± 0.66 a | - |
| 100 mL L−1 | 10.62 ± 0.29 b | 47.52 ± 0.02 c |
| 200 mL L−1 | 5.12 ± 0.13 c | 74.75 ± 0.01 b |
| 400 mL L−1 | 0 ± 0 d | 100 ± 0 a |
Publisher’s Note: MDPI stays neutral with regard to jurisdictional claims in published maps and institutional affiliations. |
© 2022 by the authors. Licensee MDPI, Basel, Switzerland. This article is an open access article distributed under the terms and conditions of the Creative Commons Attribution (CC BY) license (https://creativecommons.org/licenses/by/4.0/).
Share and Cite
Wang, B.; Lei, X.; Chen, J.; Li, W.; Long, Y.; Wang, W. Antifungal Activities of Bacillus mojavensis BQ-33 towards the Kiwifruit Black Spot Disease Caused by the Fungal Pathogen Didymella glomerata. Microorganisms 2022, 10, 2085. https://doi.org/10.3390/microorganisms10102085
Wang B, Lei X, Chen J, Li W, Long Y, Wang W. Antifungal Activities of Bacillus mojavensis BQ-33 towards the Kiwifruit Black Spot Disease Caused by the Fungal Pathogen Didymella glomerata. Microorganisms. 2022; 10(10):2085. https://doi.org/10.3390/microorganisms10102085
Chicago/Turabian StyleWang, Bingce, Xia Lei, Jia Chen, Wenzhi Li, Youhua Long, and Weizhen Wang. 2022. "Antifungal Activities of Bacillus mojavensis BQ-33 towards the Kiwifruit Black Spot Disease Caused by the Fungal Pathogen Didymella glomerata" Microorganisms 10, no. 10: 2085. https://doi.org/10.3390/microorganisms10102085
APA StyleWang, B., Lei, X., Chen, J., Li, W., Long, Y., & Wang, W. (2022). Antifungal Activities of Bacillus mojavensis BQ-33 towards the Kiwifruit Black Spot Disease Caused by the Fungal Pathogen Didymella glomerata. Microorganisms, 10(10), 2085. https://doi.org/10.3390/microorganisms10102085
